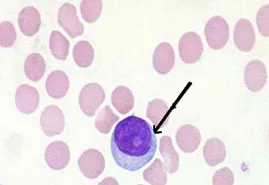
临床医学检验技术考试历年真题精练119 第2张

2026年初中级备考-今日10题
1.下列不符合血培养质量控制要求的是( )。
A.采样时严格无菌操作
B.尽量在使用抗生素前采集
C.不同部位,24小时内采集3次
D.血标本不能存放于冰箱
E.采血量大于1ml即可
【答案】E
【解析】
血培养采血每瓶不少于8ml,一般抽8~10ml。
2.不能判断失控的为( )。
A.13s
B.41s
C.22s
D.12s
E.R4s
【答案】D
【解析】
Westgard多规则质控方法中,12s规则是指一个质控结果超过平均数±2s,仅用作“警告”规则。
3.最能准确反应代谢性酸碱平衡的是( )。
A.PaCO2
B.AB
C.SB
D.动脉血pH值
E.PaO2
【答案】C
【解析】
SB是指标准状态下HCO3-的浓度,排除了呼吸对HCO3-的直接影响因而代表代谢因素,最能准确反应代谢性酸碱平衡。
4.凝固法检测血浆中游离PS,受检血浆中加入乏PS基质血浆的目的是( )。
A.稀释受检血浆
B.制作标准曲线
C.提供PS以外的其他凝血因子
D.作为正常对照
E.提供其他抗凝因子
【答案】C
【解析】
凝固法检测血浆中游离蛋白S(PS)的原理:受检血浆中加入乏PS基质血浆(提供除PS外的其他凝血因子),PS可促进APC对因子Va的抑制作用,纤维蛋白形成所需的时间与受检血浆中游离PS的量呈正相关,根据受检者凝固时间可从标准曲线中计算出游离PS的含量。
5.锌的特点不包括( )。
A.增强免疫及吞噬细胞的功能
B.促进生长发育
C.肌肉内储锌占60%
D.参与造血,影响铁的吸收和储存
E.是多种酶的激活剂
【答案】D
【解析】
肌肉内储锌占全身锌的60%,锌的功能包括增强免疫及吞噬细胞的功能;促进生长发育,促进核酸及蛋白质的生物合成;作为多种酶的功能成分或激活剂等。
6.怀疑淋病感染,操作不正确的是( )。
A.48小时培养
B.接种到冰箱内取出未预温的巧克力平皿
C.35摄氏度培养
D.含有两种抗生素以上的营养培养基
E.5%~10%CO2环境中
【答案】B
【解析】
淋病奈瑟菌是淋病的致病菌,其对环境敏感,培养的最适温度为35~37℃,应接种到预温的巧克力平皿进行培养,否则可能导致假阴性。
7.双向免疫扩散,抗体浓度小于抗原,沉淀线( )。
A.沉淀线不规则
B.在两孔中间
C.呈多条沉淀线
D.靠近抗原孔
E.靠近抗体孔
【答案】E
【解析】
双向免疫扩散中,沉淀线弯向分子量大的一方,靠近浓度低的一方,抗体浓度小于抗原,因此沉淀线靠近抗体孔。
8.空腹血糖6.2mmol/L,HbA1C8.2%,判断患者可能( )。
A.无糖尿病
B.糖耐量受损患者
C.未控制的糖尿病患
D.糖尿病发现后血糖已控制
E.新发现的糖尿病患者
【答案】B
【解析】
空腹血糖6.2mmol/L,HbA1C8.2%,均高于正常参考值。判断患者糖耐量受损。
9.IgE增高不见于( )。
A.变态反应性疾病
B.IgE型骨髓瘤
C.恶性肿瘤
D.寄生虫感染
E.系统性红斑狼疮
【答案】E
【解析】
IgE增高见于变态反应性疾病;IgE型骨髓瘤;恶性肿瘤;寄生虫感染等。系统性红斑狼疮IgE不升高。
10.如图所示,箭头所指细胞为( )。
A.中性粒细胞
B.单核细胞
C.淋巴细胞
D.网织红细胞
E.嗜碱性点彩红细胞
【答案】C
【解析】
淋巴细胞:胞体圆形,直径6~9μm,胞核圆形或有小切迹,核染色质聚集紧密成大块状。胞质量很少,颇似裸核,如可见,呈淡蓝色,一般无颗粒。
